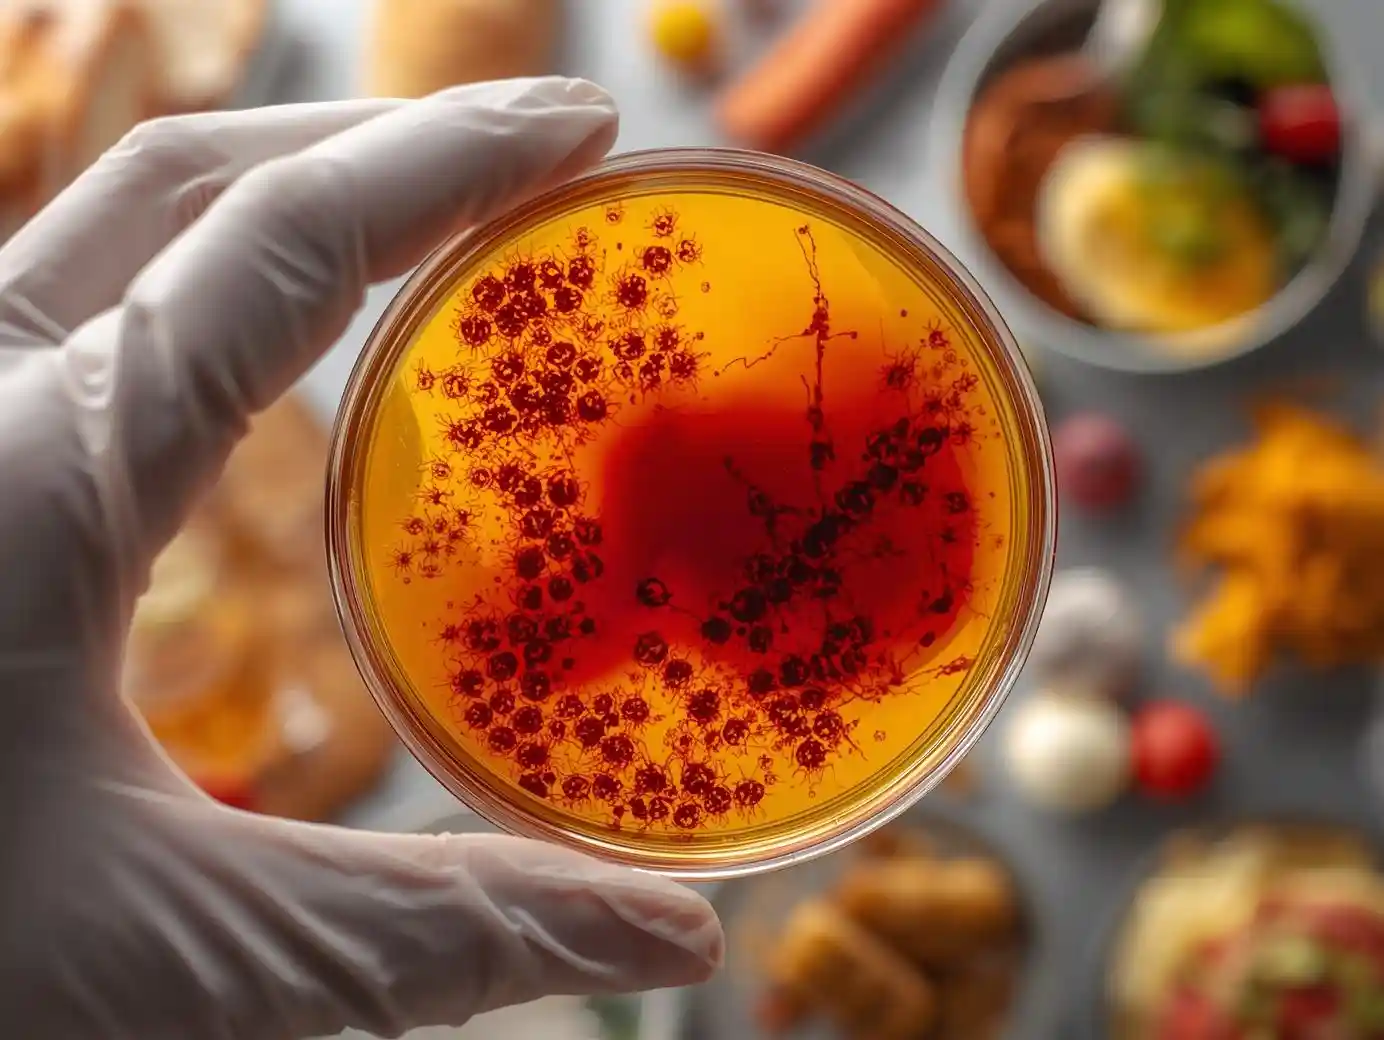
Traditional Salmonella Culture

Salmonella Testing
& Detection
PJLA-accredited Salmonella Testing using AOAC-validated PCR, lateral flow with cultural confirmation, and 3M™ Molecular Detection Assay for food, environmental, and irrigation water samples.
Precision Salmonella Testing & Food Safety
In the food industry, reliable Salmonella Testing is a non-negotiable aspect of Quality Assurance and regulatory compliance. Salmonella is a zero-tolerance foodborne pathogen. Whether you are producing Ready-to-Eat (RTE) meals, processing raw ingredients, or managing an environmental monitoring program, the risk of contamination must be managed with precision. AGT Labs provides rigorous microbiological analysis under ISO/IEC 17025:2017 and FDA LAAF accreditation to meet FSMA and GFSI requirements.
Objectives of Salmonella Testing
Key goals for a comprehensive food safety plan.
Ensure finished RTE products satisfy zero-tolerance policies requiring negative Salmonella spp. results.
Screen incoming raw materials such as spices, flour, and eggs to prevent introduction of pathogens.
Validate that your thermal kill steps (cooking/pasteurization) are effective by testing post-process samples.
Sponge and swab analysis for Zone 2 and Zone 3 areas to detect harborage niches in drains, floors, and equipment.
Accredited Salmonella Testing Methods
We employ a multi-tiered approach, offering rapid molecular screening for speed and lateral flow with cultural confirmation for regulatory defensibility. All methods are listed on our PJLA scope under ISO/IEC 17025:2017 and FDA LAAF.

Rapid Salmonella PCR
Polymerase Chain Reaction (PCR) technology amplifies specific DNA fragments unique to the Salmonella genus. The process begins with an enrichment phase to revive injured cells in the food matrix, followed by lysis to release DNA. The thermal cycler then targets and replicates Salmonella-specific genetic markers for high-sensitivity detection in food products, environmental sponges, swabs, and water.
SOP 021 | AOAC PTM # 010803 (FDA LAAF Accredited).
Advantages:This method offers high sensitivity and specificity with a rapid turnaround time. Negative results are typically available within 24 to 48 hours, allowing for the faster release of perishable food products.
Lateral Flow & Chrom ID Confirmation
This accredited method combines a rapid lateral flow immunoassay with cultural confirmation on selective chromogenic media. Samples undergo pre-enrichment to recover stressed cells, followed by selective enrichment, lateral flow screening, and confirmation on Chrom ID or Hardy Chrom agar. This pathway is validated for environmental sponges, swabs, food products, and water matrices.
SOP 020 | AOAC PTM # 080601 (FDA LAAF Accredited).
Advantages:Lateral flow gives a fast presumptive read while the cultural confirmation step isolates the living organism on selective agar — essential for regulatory disputes, root-cause investigations, and defensible Certificates of Analysis.

3M™ Molecular Detection Assay (MDA)
A real-time isothermal amplification platform validated for the detection of Salmonella in food, environmental samples, and irrigation water. After enrichment, target nucleic acids are amplified and detected by bioluminescence, providing rapid, definitive presumptive results suitable for high-volume production environments and Produce Safety Rule compliance for irrigation water.
AOAC 2016.01 | GENE-UP® Salmonella 2 (AOAC 2020.02) available as alternate validated platform.
Advantages:Provides validated detection for irrigation water and complex food matrices, with quantification (AOAC PTM # 082104) available when an enumeration result is required.
Matrices Validated for Salmonella Testing
Our PJLA scope covers food products, environmental sponges and swabs, water, irrigation water, and pet food.

Raw Poultry & Meat

Eggs & Egg Products

Low Moisture Foods

Chocolate & Cocoa

Produce & Irrigation Water

Spices, Environmental Swabs & Pet Food
Why Choose AGT Food Labs?
We combine technical rigor with the agility of a dedicated safety partner.
ISO/IEC 17025:2017 Accredited by PJLA & FDA LAAF Recognized. Your results are legally defensible.
We understand that shelf life is critical. Our lab offers expedited workflows to minimize inventory hold times.
In the event of a positive finding, our microbiologists provide guidance on root cause analysis and remediation strategies.
Common Questions About Salmonella Testing
Why is "Zero Tolerance" applied to Salmonella in RTE foods?
What is the difference between rapid PCR and lateral flow with cultural confirmation?
How much sample is needed?
Should I test finished products or the environment?
What happens if my sample tests presumptive positive?
Related Safety & Stability Services
Ensure your products are free from all major pathogens with these complementary services.
Listeria Detection
Crucial for facility hygiene and RTE safety. We offer rapid PCR and cultural methods for Listeria monocytogenes.
Foodborne Pathogens
Full-spectrum detection for STEC E. coli, Campylobacter, and other accredited pathogens to ensure complete consumer safety.
Food Hygiene Indicators
Monitor general sanitation effectiveness using APC, Coliforms, and Yeast & Mold to prevent pathogen harborage.
Prevent Salmonella Recalls
Validate your sanitation protocols with PJLA-accredited Salmonella Testing.
Get A Free Quote